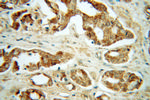
GNS Antibody in Immunohistochemistry (Paraffin) (IHC (P))

Search
Proteintech
GNS Polyclonal Antibody
{{$productOrderCtrl.translations['antibody.pdp.commerceCard.promotion.promotions']}}
{{$productOrderCtrl.translations['antibody.pdp.commerceCard.promotion.viewpromo']}}
{{$productOrderCtrl.translations['antibody.pdp.commerceCard.promotion.promocode']}}: {{promo.promoCode}} {{promo.promoTitle}} {{promo.promoDescription}}. {{$productOrderCtrl.translations['antibody.pdp.commerceCard.promotion.learnmore']}}
产品信息
13044-1-AP
种属反应
已发表种属
宿主/亚型
分类
类型
抗原
偶联物
形式
浓度
规格
纯化类型
保存液
内含物
保存条件
运输条件
产品详细信息
Immunogen sequence: SVDYLTDVL ANVSLDFLDY KSNFEPFFMM IATPAPHSPW TAAPQYQKAF QNVFAPRNKN FNIHGTNKHW LIRQAKTPMT NSSIQFLDNA FRKRWQTLLS VDDLVEKLVK RLEFTGELNN TYIFYTSDNG YHTGQFSLPI DKRQLYEFDI KVPLLVRGPG IKPNQTSKML VANIDLGPTI LDIAGYDLNK TQMDGMSLLP ILRGASNLTW RSDVLVEYQG EGRNVTDPTC PSLSPGVSQC FPDCVCEDAY NNTYACVRTM SALWNLQYCE FDDQEVFVEV YNLTADPDQI TNIAKTIDPE LLGKMNYRLM MLQSCSGPTC RTPGVFDPGY RFDPRLMFSN RGSVRTRRFS KHLL (200-552 aa encoded by B C012482)
靶标信息
GNS is a lysosomal enzyme found in all cells. It is involved in the catabolism of heparin, heparan sulphate, and keratan sulphate. Deficiency of this enzyme results in the accumulation of undegraded substrate and the lysosomal storage disorder mucopolysaccharidosis type IIID (Sanfilippo D syndrome). Mucopolysaccharidosis type IIID is the least common of the four subtypes of Sanfilippo syndrome.
仅用于科研。不用于诊断过程。未经明确授权不得转售。
生物信息学
蛋白别名: G6S; glucosamine (N-acetyl)-6-sulfatase isoform GNS_1; glucosamine (N-acetyl)-6-sulfatase isoform GNS_2; glucosamine -6-sulfatase; Glucosamine-6-sulfatase; N-acetylglucosamine-6-sulfatase; unnamed protein product
基因别名: 2610016K11Rik; AU042285; C87209; G6S; GNS; N28088
UniProt ID: (Human) P15586, (Mouse) Q8BFR4
Entrez Gene ID: (Human) 2799, (Mouse) 75612, (Rat) 299825